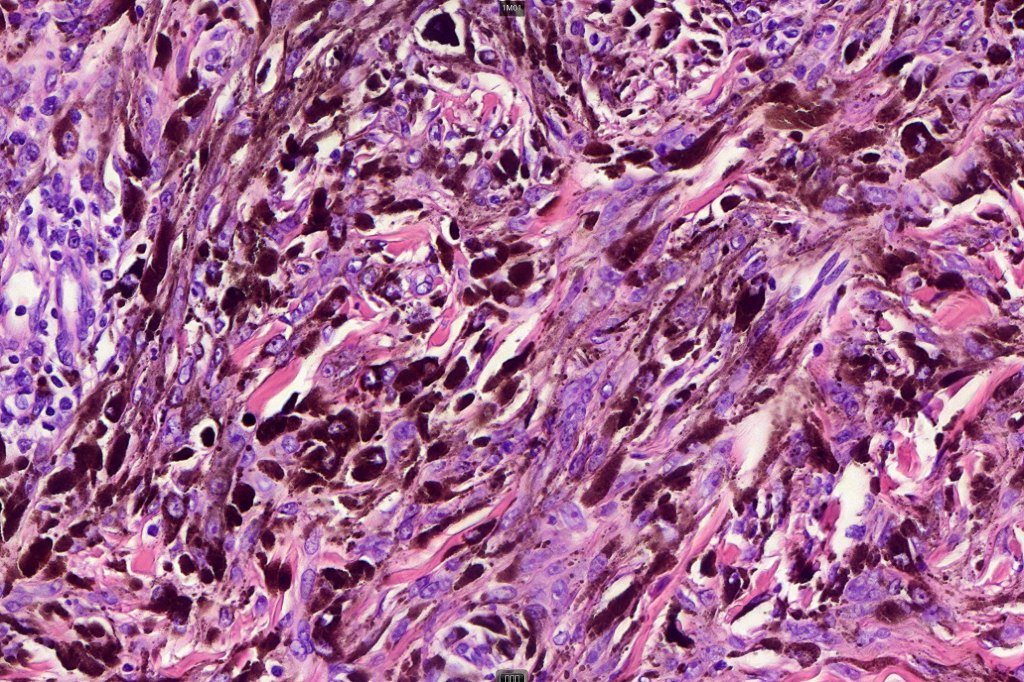

In the older literature this lesion has previously been called epithelioid blue nevus, animal type melanoma, pigment synthesizing melanoma & equine melanoma. Indeed, my cases of so-called animal type melanoma were re-classified as pigmented epithelioid melanocytoma during the preparation of the seminal paper on the topic by Zembowicz & Carney.
Clinical features
•Most common in the 2nd-4th decades but may present in infants & children
•M=F
•No site predilection
•1.0 cm or larger brown, blue black or black nodules
•More commonly sporadic
•Less often form part of Carney complex
•Sentinel node +ve in 41%
•Very rare distant metastases although the outcome is generally favorable
Histological features, immunohistochemistry & molecular changes
•Dermal of less often compound
•Wedge shape or less often plaque like silhouette
•Commonly associated with marked acanthosis/pseudoepitheliomatous hyperplasia although much less commonly, the epidermis is strteched over the lesion
•Sometimes presents as a combined lesion- banal or Spitzoid
•Composed of an admixture of large epithelioid melanocytes with vesicular nuclei containing a very prominent nucleolus (fried egg cells), spindle cells, dendritic cells & melanophages
•The epithelioid cells are typically very uniform
•Few mitoses
•Perineural infiltration sometimes evident
•Absent necrosis & lymphovascular invasion
•Variable molecular changes including fusions in PRKCA), mutations in PRKAR1A & mutations in PRKAR1A and BRAF (in combined lesions)
•S100, SOX10, HMB45 & Melan-A +ve
•PRKAR1A –ve except for tumors associated with PRKCA fusions

Leave a comment